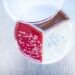
Türk bilim insanlarından Kovid-19 araştırmalarına katkı verecek yeni keşif

Seyircisini özleyen tiyatroculardan çağrı: #BizdeYerinAyrı
Tiyatro Kooperatifi’nin başlattığı #BizdeYerinAyrı destek programı ile seyirciler yeni sezondaki yerlerini bugünden alıp tiyatrolara destek verebilecek.
#BizdeYerinAyrı seyirci destek programı tüm tiyatroseverleri özel tiyatrolar için dayanışmaya çağırıyor! COVID-19 salgını nedeniyle bütün gelirleri kesilen ve zor günler geçiren özel tiyatrolara katkı sağlanabilmesi için Tiyatro Kooperatifi tarafından, #BizdeYerinAyrı başlığı altında bir seyirci destek programı başlatıldı. “Şimdi ayrı olsak da #BizdeYerinAyrı” sloganıyla tiyatroların seyircilerine olan özlemini dile getiren destek programına katılım sağlayan tiyatroseverler, yeni sezonda tiyatrolarda yerlerini önden alarak bugünden tiyatroların, tiyatro oyuncularının ve tiyatro emekçilerinin yanında olabilecek. Değişik şeçenekler halinde hazırlanan destek programının paketlerine mobilet.com sitesinden erişilebiliyor.
Farklı ücretlerde birçok paket sunarak herkesin tiyatroya destek olabilmesine imkân sağlayan #BizdeYerinAyrı programına ait paketler, hem bireyler hem de kurumlar tarafından satın alınabiliyor. Paketleri satın alanlar, 30 Haziran 2021 tarihine kadar, programa dahil olan tiyatroların sahnelediği oyunlara bugünden rezervasyon yaptırabiliyor.
PROGRAMA 25 TİYATRO DAHİL
Programa dahil olan kooperatif ortağı tiyatrolar ise; Altkat Sanat Atölyesi, Altsahne, Ankara Birlik Tiyatrosu, Asmalı Sahne, Baba Sahne, Balkonda Sanat, DasDas, GalataPerform, ikincikat, Kadıköy Theatron, Levent Üzümcü Tiyatrosu, NoAct Sahne, ÖyküSahne, TiyatroAçıkça, Tiyatro Yeniden, Tatavla Tiyatro, Tatavla Sahne, Tiyatro BeReZe, Tiyatro D22, Tiyatro Dalga, Tiyatro Öteki Hayatlar, Yolcu Tiyatro, Gaca Tiyatro, K! Kültüral Performing Arts ve Pangea-UNIQ İstanbul’dan oluşuyor.
Tiyatro Kooperatifi’nin başlattığı #BizdeYerinAyrı programının sunduğu paketlerin detaylarına bizdeyerinayri.com ve mobilet.com sitelerinden ulaşılabilir.